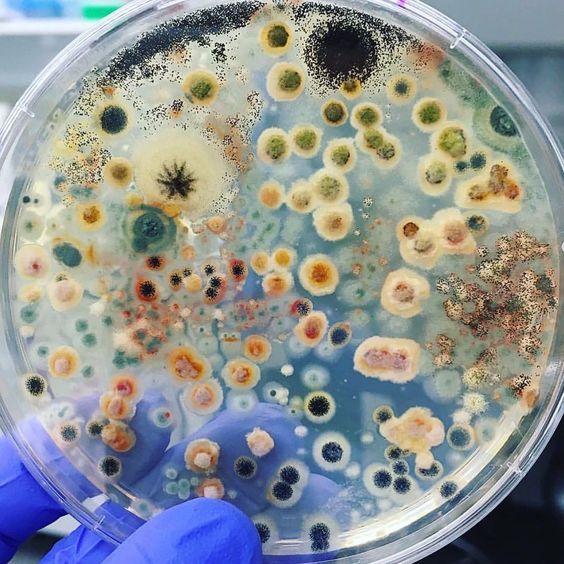

실내 '습윤,곰팡이'환경이 정신 건강을 망친다? -스트레스 염증 관점으로 읽는 최신 연구 정리
"요즘 이유 없이 예민해지고 우울해요."
여러분 중 많은 분이 이렇게 말합니다.
단순한 스트레스일까요 ?
아니면 집 안 '습기, 곰팡이'가 눈에 보이지 않게 기분과 기억에 영향을 주는 걸까요?
최근 체계적 리뷰와 실증 연구들은 주거지의
눅눅함(습윤), 곰팡이 노출이 우울증, 불안, 인지 저하와 유의한 연관을 보인다고 보고합니다.
이는 단발성 보고가 아니라 여러 국가의 역학, 임상, 동물 실험 결과로 뒷받침됩니다.
1) 역학 증거 - 눅눅한 집과 '우울, 불안'이 연결된다
대규모 인구 기반 연구와 스코핑 리뷰에서 주거 내 습기/곰팡이 노출이
정신건강 지표(우울증·불안증상) 증가와 관련 있다는 보고가 반복적으로 확인됩니다.
특히 노년층, 저소득층, 난방, 환기가 취약한 주택 거주자에서 효과
크기가 더 크게 관측된 연구들이 최근에 추가로 발표되었습니다.
핵심-역학 자료는 연관성(association)을 강하게 시사하지만,
모든 개인에게 곧바로 인과(원인-결과)를 의미하진 않습니다.
다만 공중보건 차원에서는 충분히 중요한 신호입니다.
2) 메커니즘 -왜 '눅눅함'이 마음(뇌)에 닿는가? (염증 + 스트레스 축)
연관성이 관찰되는 이유는 크게 두 축으로 설명됩니다.
1.면역·염증 경로 (Peripheral > Central inflammation)
곰팡이, 습윤 환경은 호흡기 점막 자극과 면역반응을 통해 시스템성 염증(예: TNF-α, IL-6 증가) 을 유발할 수 있습니다.
이 염증 신호는 혈류를 통해 뇌에 전달되어 신경염증을 일으킬 수 있으며,
이는 우울·인지저하와 밀접한 관련이 있습니다.
2.신경내분비 축(HPA axis) 과항진 > 스트레스 반응
습윤, 곰팡이로 인한 만성 자극은 HPA 축을 지속적으로 활성화시켜 코르티솔 등 스트레스 호르몬 분비 증가를 초래합니다.
장기적으로는 수면장애, 불안, 기분저하와 연결됩니다.
이 기전은 환경노출이 정신장애에 영향을 미치는 일반적 이론과 일치합니다.
한 문장 요약-공기(곰팡이 포자, MVOC) > 호흡기 자극 > 면역·염증 신호 상승 > 뇌의 신경염증, 호르몬 이상 > 기분,인지 변화라는 연쇄가 과학적으로 제시되고 있습니다.
3) 증거의 강도와 한계 - 무엇을 신뢰해야 하나?
체계적 리뷰(최근 EHP 리뷰)-전반적으로 '눅눅함/곰팡이와 정신건강의 양(+)의 연관'결과가 많이 수집됨.
다만 측정(자기보고 vs 실측), 교란요인(소득, 기저질환) 통제가 연구마다 달라 이질성(heterogeneity)이 큽니다.
인과성 증명-동물·세포 실험은 염증, 신경독성 경로를 지지하지만, 인간에서의 직접적 인과관계
('곰팡이 노출이 곧 정신질환 유발')는 아직 증거 축적이 더 필요합니다.
따라서 임상적 판단은 증상, 환경을 함께 고려해야 합니다.
4.실생활 관찰, 사례 - 어떤 사람이 더 취약한가?
어린이, 청소년-성장기 뇌 발달에 노출이 불리하게 작용할 수 있어 주의 권고.
(습윤 주택 거주 어린이의 염증 표지자 상승 보고)
노인과 기저질환자-면역, 인지 취약성으로 영향받기 쉬움.
심리적 매개-집을 통제할 수 없다는 인식(무력감)이 중간 매개자로 작용해
우울감을 심화시킬 수 있다는 사회심리적 연구도 있습니다.
5.자가진단 체크리스트 - 내 집, 내 증상, 한번 점검해보세요 (간단)
환경 신호(하나라도 해당하면 주의)
1.욕실, 벽, 창틀에 곰팡이 얼룩이 있다
2.집에 눅눅한 냄새(퀴퀴함)가 지속된다
3.결로, 누수가 자주 발생한다
4.건강 신호(세 가지 이상 해당하면 전문가 상담 고려)
5.이유 없이 우울하거나 불안하다
6.집중력, 기억력이 평소보다 현저히 떨어짐
7.만성 피로, 수면장애가 있다
6.행동 가이드 당장 무엇을 할 것인가 (우선순위 5단계)
1.습도 관리(우선)-실내 상대습도 40~60% 권장. 제습기, 환기, 배기팬 사용.
2.가시적 곰팡이 즉시 제거-소규모는 전용 세정(통풍, 보호구 착용). 광범위, 재발 시 전문 시공 권장.
3.공기질 점검-가능하면 곰팡이 포자, VOCs 측정(감지기/전문기관). 데이터 기반 대응으로 재발 감소.
4.생활 습관, 건강관리 병행-수면, 운동, 항염 영양(오메가-3, 항산화)으로 염증, 정서 관리 보완.
5.증상이 심하면 전문가 상담-호흡기, 피부(알레르기), 정신건강(우울, 불안) 중 증상 발생 시 의료진과 환경평가 병행 권장.
7.증명 되어 있는 자료 더 보기 (추천 원문)
1.A State-of-the-Science Review - Damp- and Mold-Affected Housing on Mental Health,
Environmental Health Perspectives (리뷰)
2.Human Health Effects Associated with Damp Indoor Environments, NCBI/WHO 보고(공중보건 정리)
3.Psychological effects of mould and damp in the home: scoping review (2023)
4.Moisture damage in home associates with systemic inflammation in children (연구 사례)
핵심 정리 - 공기질은 '보이는' 건강만이 아니라 '보이지 않는' 마음을 지키는 문제입니다
실내 습윤, 곰팡이 문제는 단순한 미관, 냄새 문제가 아닙니다.
최신 연구는 호흡을 통해 들어오는 환경 스트레스(습도, 곰팡이 포자)가
면역, 염증, 신경내분비 경로를 자극해 정신건강에 영향을 줄 수 있다고 보고합니다.
다만 모든 사례가 동일한 메커니즘으로 진행되는 것은 아니므로
증상, 환경, 검사를 함께 고려한 접근이 필요합니다.
'곰팡이' 카테고리의 다른 글
| 스탁키보트리스(Stachybotrys chartarum) 과대 정보와 실제 건강 리스크 정리 (5) | 2025.08.12 |
|---|---|
| 공기 중 곰팡이 독소 측정 기술 비교-효소 기반, 분자진단, VOC 측정 등 (1) | 2025.08.12 |
| 곰팡이 포자 농도(CFU/m³)와 정신 인지 기능 저하의 상관관계 실증 연구 비교 (2) | 2025.08.12 |
| 젊은 층 및 아이들에게 곰팡이 노출이 끼치는 심리적 행동적 영향 사례 분석 (4) | 2025.08.11 |
| 트리코테센 Fumonisin B1 등의 마이코톡신이 신경내분비,정신 증상 유도 메커니즘 (4) | 2025.08.07 |
| 오크라톡신A(Ochratoxin A)의 뇌 독성 및 알츠하이머 연관성 (1) | 2025.08.07 |
| 실내 곰팡이 > 뇌 질환, 기억력 저하까지? 최신 연구 정리 (4) | 2025.08.06 |
| 곰팡이 제거 전문가가 말하는 ‘진짜 원인’ (0) | 2025.07.27 |